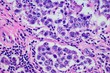
Image

-

05 Nov 2015
Nerve cell damage repaired by protein
by MariAnna Lane
- Views 3024
- More stats
-

25 May 2017
Zika virus likely circulated in Americas long before its detection
by Massachusetts Institute of Technology
- Views 2963
- More stats
-
23 May 2017
Study offers guidance for targeting residual ovarian tumors
by Massachusetts Institute of Technology
- Views 2889
- More stats
-

23 Aug 2016
The launch of a new career portal: Science HR
by Alen Piljić
- Views 2825
- More stats
-

25 May 2017
Researchers engineer shape-shifting noodles
by Massachusetts Institute of Technology
- Views 2779
- More stats
-

11 Oct 2017
Research Elements Association founded
by Alen Piljić
- Views 2715
- More stats
-

31 Mar 2015
Summer School of Science
by Matilda Males
- Views 2658
- More stats
-

20 Jul 2018
Science Events – A new web application to help you organise a scientific event
by Alen Piljić
- Views 2567
- More stats
-

04 Jan 2016
Affymetrix Tumor Profiling Grant Program
by Aleksander Benjak
- Views 2481
- More stats
-

07 Apr 2014
Alternative Medicine Revealed as Possible IVF Improvement
- Views 2478
- More stats
Latest News in Life Sciences
Read the latest news, announcements and press releases from life sciences and related disciplines, including news from biotechnology and pharmaceutical research and development. When you join Life Science Network, you can follow your favorite sources to get notified when content matching your interests is published.
You can post a news article here
Join Life Science Network
Join LSN to acces all jobs and fully benefit from the platform and its features.
News module
Are you interested in posting articles on Life Science Network?
Please continue reading here.
For more information about Life Science Network,
contact us at [email protected].
Loading ad...